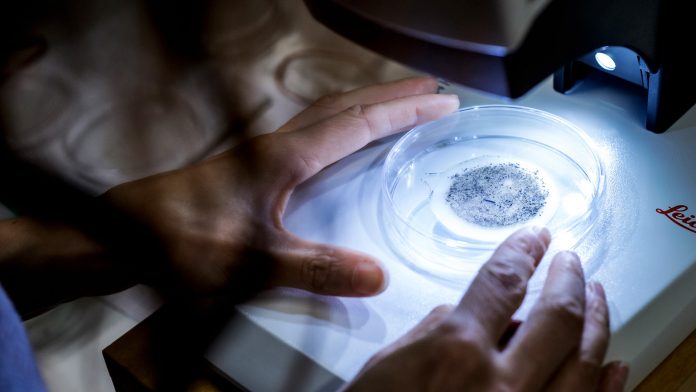

Researchers at the University of Eastern Finland, University of Turku, and University of Helsinki have developed a new method for the temporal monitoring of microplastics in sediment.
Microplastics have been found in nearly all organisms and habitats everywhere in the world. However, factors contributing to the influx and accumulation of microplastics in sediment and the water ecosystems are not fully understood yet. The focus of microplastics research has been on the age of microplastics found in sediments, and on the time it takes to accumulate there. So far, temporal changes in sedimentation have not been considered in microplastics research.
In their recent paper published in Environmental Pollution, the team explain: ‘Detailed temporal measurements of microplastic flux rates are needed for investigating the accumulation rate of microplastics in different environments and for understanding the change in microplastic concentrations through time. Long-term observations reveal the rate and direction of change in microplastic flux rate with respect to sediment influx. This type of information is crucial for modelling microplastic accumulation in the future’.
Using the sediment trap method
The research team in Finland has tested the sediment trap method to analyse annual accumulation rates and possible seasonal variation. The sediment trap was installed on the lake bottom in the deepest part of the basin. Microplastics sink to the bottom of the basin together with other solid material and they accumulate in sediment traps that are emptied on a regular basis.
The sediment trap is a well-established method for sedimentological studies. The main focus in the development of the method was on the isolation of microplastic samples from sediment and on testing the method’s feasibility in a body of water.
The researchers tested the method in the basin of Huruslahti Bay, Finland, in 2017–2018. The annual amount of microplastics accumulating in the sediment of Huruslahti Bay was 32,400 pieces per square metre. The most important advantage of the method is that it can be used to determine the time it takes for microplastics to enter and accumulate in bodies of water. Time plays an important role when modelling the influx and accumulation of microplastics, as well as in predicting any environmental risks they might cause in the future.